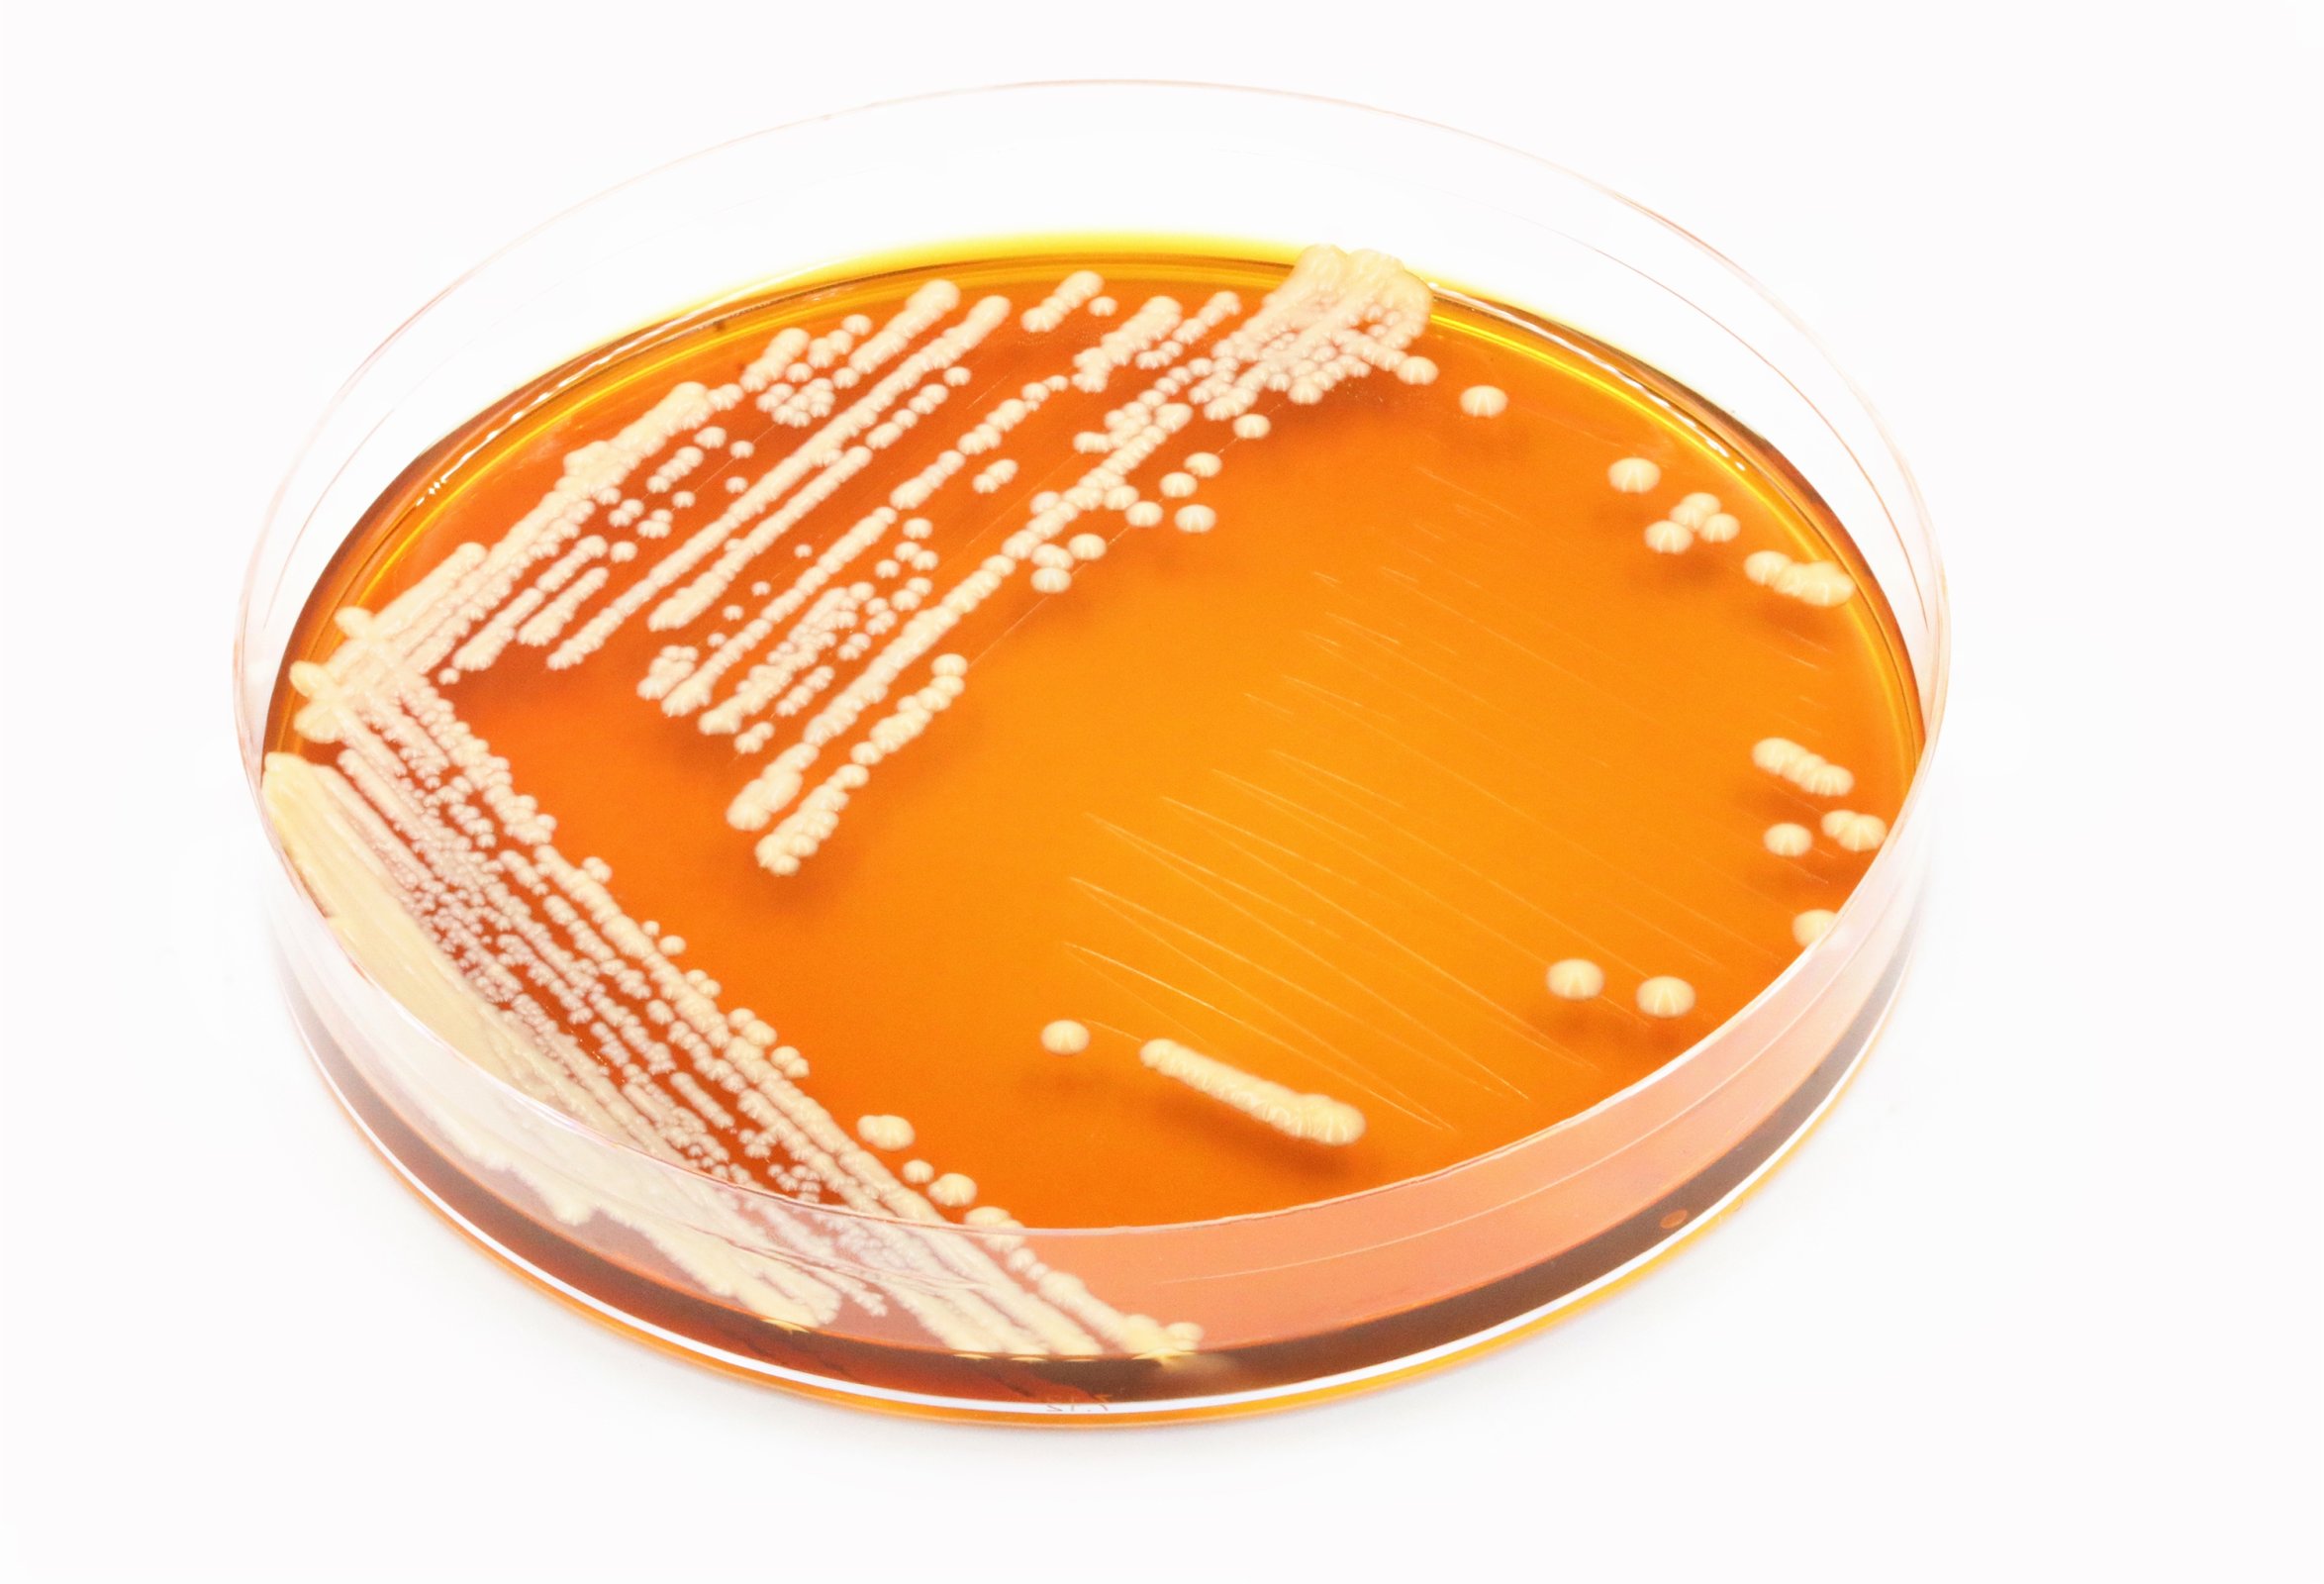

Saccharomyces
Mykologie
[Sacharomycés, řečtina], sacharomycety – rod kulovitých až vejčitých hub (kvasinek) z třídy Ascomycetes. Množí se vegetativně, pučením. Pro své kvasné vlastnosti (tvorbu CO2 k a alkoholu) jsou významné v kvasném průmyslu. Dělí se na kvasinky kulturní a divoké, pivovarské, vinařské a pekařské á většinou však jde o různé variety druhu Saccharomyces cerevisiae, jichž bylo dosud izolováno 1400. Nejvýznamnějšími zástupci jsou: Saccharomyces carlsbergensis a Saccharomyces uvarum, využívané zejména v pivovarnictví. Patogenní pro člověka může být Saccharomyces fragilis, původce některých sepsí a akutních bronchopneumonií.
Vytvořeno:
14. 3. 2000
Aktualizováno:
14. 8. 2006
Autor: -red-
Odkazující hesla: mykoviry.
Vyzkoušejte si s přáteli Kvízy encyklopedie CoJeCo.cz!